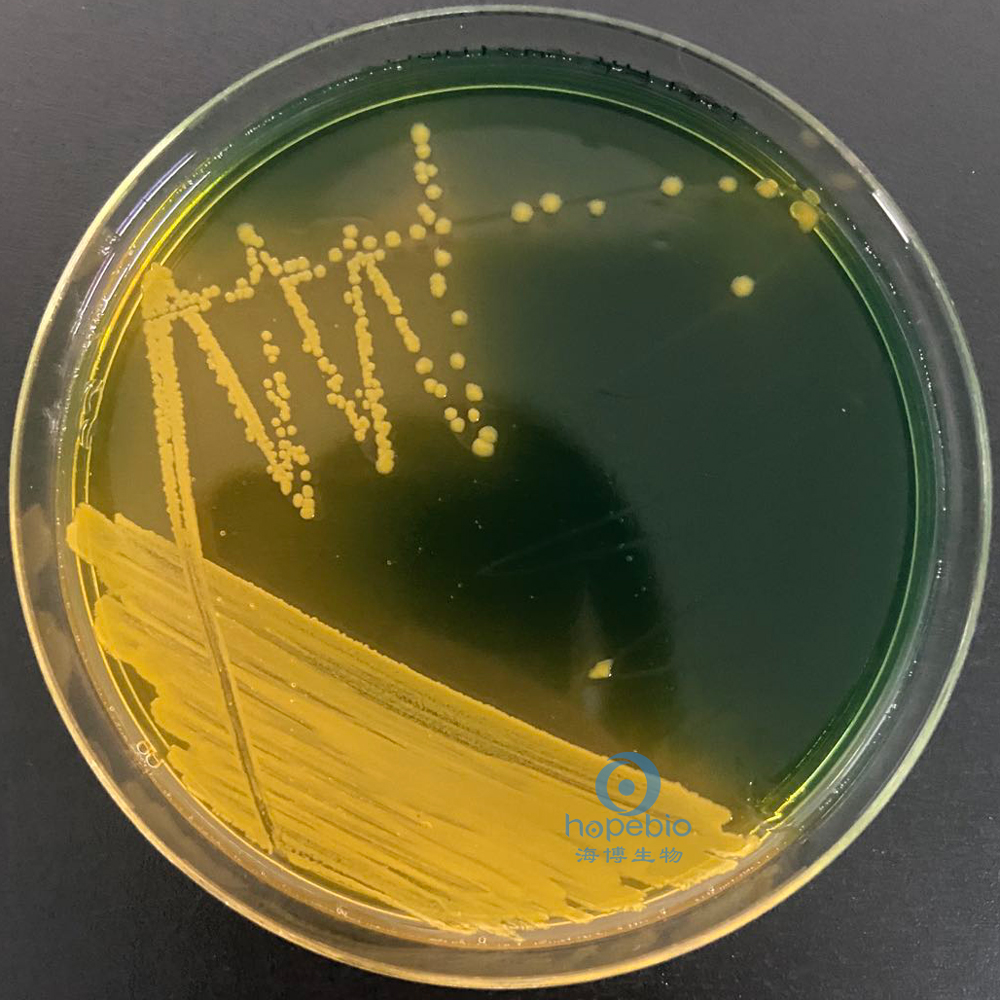
霍乱弧菌分型鉴定,霍乱弧菌的鉴定方法有几种
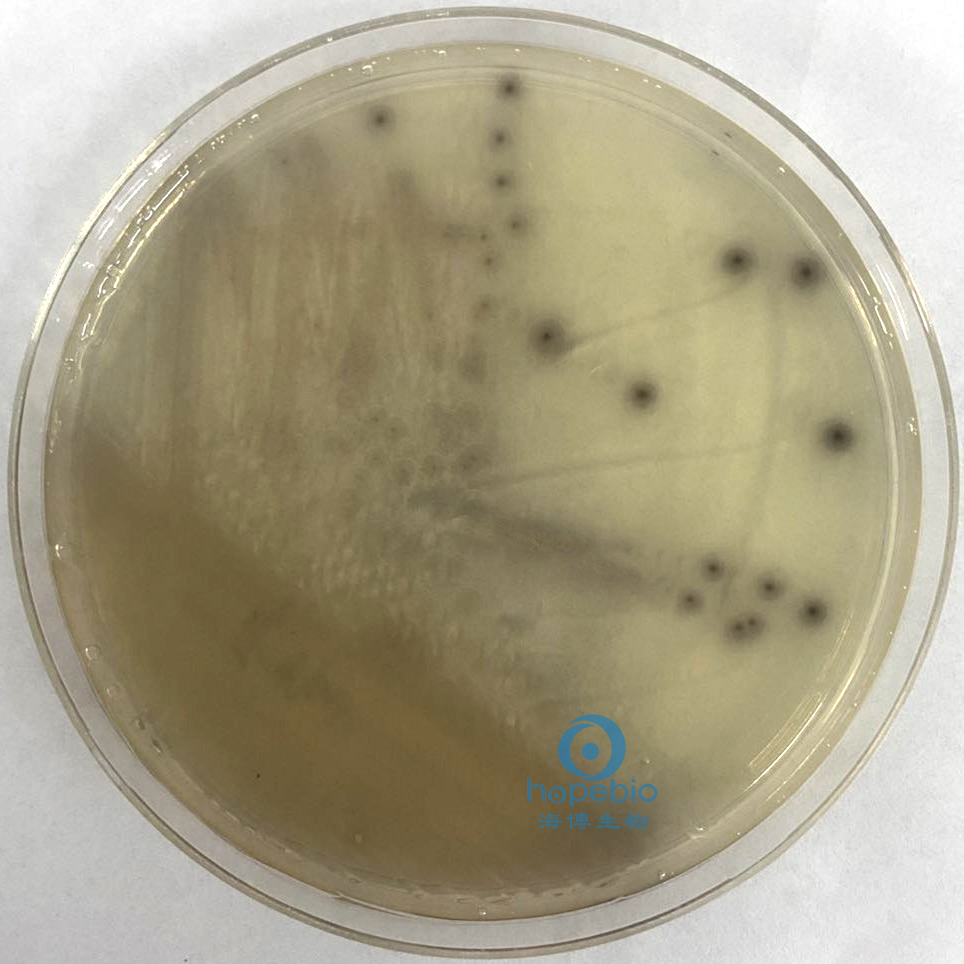
霍乱弧菌分型鉴定,霍乱弧菌的鉴定方法有几种

一、前言
1.生物学特征
霍乱弧菌(Vibrio cholerae)为革兰氏阴性菌,呈弧形或逗点状,无芽胞,有菌毛,有些菌株有荚膜,一端有一根粗而长的鞭毛,运动活泼。取霍乱病人米泔水样粪便作活菌悬滴观察,可见细菌运动极为活泼,呈穿梭样或流星状运动。液体培养物滴片染色镜检,可见排列如“鱼群状”弧菌。经人工培养后,易失去弧形而呈杆状。
营养要求不高,在普通培养基上生长良好,在pH 6.8-10.2范围均可生长,耐碱,在pH 8.8-9.0的碱性蛋白胨水或平板中生长良好,因其他细菌在这pH不易生长,故碱性蛋白胨水可作为选择性增殖霍乱弧菌的培养基。
在碱性平板上菌落直径为2mm,圆形,光滑,透明。霍乱弧菌对热,干燥,日光,化学消毒剂和酸均很敏感,耐低温:湿热55℃,15分钟,100℃,1-2分钟,水中加0.5ppm氯15分钟可被杀死;0.1%高锰酸钾浸泡蔬菜、水果可达到消毒目的;在正常胃酸中仅生存4分钟。霍乱弧菌为需氧或兼性厌氧菌,在16-44℃均可生长,最适生长温度37℃。
2.流行病学特征
霍乱弧菌(Vibrio cholerae)是霍乱的病原菌,该病为一种急性烈性肠道传染病,主要表现为剧烈的呕吐,腹泻,失水,发病急,传染性强,死亡率高,属于国际检疫传染病。共分为139个血清群,其中O1群和O139群可引起霍乱。霍乱弧菌O1群和O139群是烈性肠道传染病霍乱的病原体。在自然情况下,人类是霍乱弧菌的易感者。人通过摄入霍乱弧菌污染的食物或水,引起霍乱。进入肠道的霍乱弧菌通过鞭毛运动穿过肠黏膜表面的黏液层,接近肠黏膜上皮细胞,通过普通菌毛的作用定植。肠道内的环境有利于霍乱弧菌的繁殖,产生霍乱肠毒素,导致疾病的发生。
霍乱弧菌的主要致病因素是霍乱毒素(cholera toxin,CT),CT是目前已知的致泻毒素中最强烈的毒素,可造成肠液大量分泌,导致严重的呕吐和腹泻,使体内水分和电介质大量丢失,形成严重的水样腹泻综合征。霍乱弧菌造成的主要病变均由严重脱水引起,临床可见指纹皱缩,皮下组织及肌肉干瘪。心、肝、脾等脏器均见缩小。内脏浆膜无光泽。肠腔高度扩张、肠内充满泔水样液体,肠粘膜松弛,但粘膜上皮完整,无溃疡。胆囊内充满粘稠胆汁。肾小球及间质的毛细管扩张,肾小管肿胀、变性及坏死。其他脏器也有出血、变性等变化。
二、检验过程
试验参考标准为《SN/T 1022—2010 进出口食品中霍乱弧菌检验方法》。本标准规定了进出口食品中霍乱弧菌(Vibrio cholerae)的检验方法,适用于食品中霍乱弧菌的检验,动物饲料和其他食品生产和加工区域环境样品中的霍乱弧菌检验可参照使用。
霍乱弧菌检验程序如图1:

图1
1.培养基鉴定及结果判断
①TCBS培养基
原理:蛋白胨、酵母浸粉提供碳氮源、维生素和生长因子;氯化钠可刺激弧菌的生长;蔗糖是可发酵的糖类;牛胆酸钠、牛胆粉、硫代硫酸钠和枸橼酸钠及较高的pH 可抑制革兰氏阳性菌和大肠菌群;硫代硫酸钠与柠檬酸铁反应作为检测硫化氢产生的指示剂;溴麝香草酚蓝和麝香草酚蓝是pH指示剂;琼脂是培养基的凝固剂。
使用方式:称取本品89g,煮沸溶解于1000ml蒸馏水中,冷至45-50℃时,倾入无菌平皿,备用。注:无需高压灭菌。
结果:霍乱弧菌在TCBS上呈圆形,表面光滑,黄色,直径2mm~3mm,具体试验结果如图2:
图2 霍乱弧菌非01 TCBS培养基生长结果
②庆大霉素琼脂培养基
原理:蛋白胨、牛肉浸粉提供氮源、维生素、矿物质和生长因子;蔗糖提供碳源;氯化钠即用于满足霍乱弧菌嗜盐生长的要求,同时形成了不利于其他细菌生长的高渗透压;亚硫酸钠可刺激弧菌生长;庆大霉素和亚碲酸钾及较高的pH值,可抑制革兰氏阳性菌和部分革兰氏阴性杂菌的生长;枸橼酸钠可使得霍乱弧菌免受其他抑菌物质的影响;霍乱弧菌对酸性环境比较敏感,因此该pH 值可促进其生长;琼脂是培养基的凝固剂。
使用方式:称取本品56.0g,加热搅拌溶解于1000ml蒸馏水中,冷至50℃左右时,加入无菌1%亚碲酸钾溶液0.5ml,混匀,倾入无菌平皿,备用。无需高压灭菌。
结果:霍乱弧菌在庆大霉素琼脂培养基上略带青灰色,半透明,扁平微隆起,如延长培养或室温放置,菌落中心形成黑色金属碲沉淀,具体试验结果如图3:

菌落略带青灰色,半透明,扁平微隆起
延长培养时间后,菌落中心形成黑色金属碲沉淀
③氯化钠三糖铁琼脂
原理:蛋白胨、牛肉浸粉、酵母浸粉提供碳氮源、维生素和矿物质;乳糖、葡萄糖、蔗糖为可发酵糖类,其被分解产酸时通过苯酚红酸碱指示剂测出,酸性呈黄色,碱性呈红色;因某些细菌能分解含硫氨基酸,生成硫化氢,硫化氢和培养基中的铁盐反应生成黑色的硫化亚铁沉淀;较高含量的氯化钠可促进弧菌的生长;琼脂是培养基的凝固剂。
使用方式:称取本品69.5g,加入1000ml蒸馏水中,加热煮沸使完全溶解,分装试管,121℃高压灭菌15分钟,备用。
结果:霍乱弧菌在氯化钠三糖铁斜面上的反应为底层黄色,斜面黄色,不产生硫化氢,不产气,具体试验结果如图4:

④氯化钠营养琼脂
原理:蛋白胨、牛肉浸粉提供微生物生长所需的碳氮源、维生素和生长因子;高含量的氯化钠可促进霍乱弧菌的生长;琼脂是培养基的凝固剂。
使用方式:称取本品36.0g,加热溶解于1000ml蒸馏水中,分装三角瓶或试管,121℃高压灭菌15min,备用。
结果:霍乱弧菌在氯化钠营养琼脂培养基上纯化培养后菌落呈圆形,边缘半透明中央不透明,直径为3mm左右,具体试验结果如图5:

2.生化鉴定及结果判断
①革兰氏染色
所用试剂:革兰氏染色液试剂盒。
原理:通过结晶紫初染和碘液媒染后,在细胞壁内形成了不溶于水的结晶紫与碘的复合物,革兰氏阳性菌由于其细胞壁较厚、肽聚糖网层次较多且交联致密,遇乙醇或*酮丙**脱色处理时,因失水反而使网孔缩小,再加上它不含类脂,因此,能把结晶紫与碘复合物牢牢留在壁内,使其仍呈紫色;而革兰氏阴性菌因其细胞壁薄、外膜层类脂含量高、肽聚糖层薄且交联度差,在遇脱色剂后,以类脂为主的外膜迅速溶解,薄而松散的肽聚糖网不能阻挡结晶紫与碘复合物的溶出,因此通过乙醇脱色后仍呈无色,再经沙黄等红色染料复染,就使革兰氏阴性菌呈红色。
结果:霍乱弧菌为革兰氏阴性菌,呈弧形或弯曲状,染色结果如图6:

②氧化酶试验
所用试剂:氧化酶试纸。
原理:氧化酶亦即细胞色素氧化酶,为细胞色素呼吸酶系统的终末呼吸酶,氧化酶先使细胞色素c氧化,然后此氧化型细胞色素c再使对苯二胺氧化,产生颜色反应。用细玻璃棒或一次性接种针挑取单个菌落,涂在试纸上。在30s内变为蓝色或蓝紫色为阳性,不变色为阴性。
结果:挑选营养琼脂上纯培养的单个菌落进行氧化酶试验,霍乱弧菌为氧化酶阳性,试验结果如图7:

③生化鉴定条试验
所用试剂:青岛海博HBI霍乱弧菌生化鉴定条(SN)。
试剂介绍:用于霍乱弧菌的生化鉴定。组成:ONPG、尿素酶、明胶、精氨酸双水解酶肉汤、鸟氨酸脱羧酶肉汤、赖氨酸脱羧酶肉汤、氨基酸脱羧酶对照、无盐胰胨水、2%氯化钠胰胨水、6%氯化钠胰胨水、8%氯化钠胰胨水、10%氯化钠胰胨水、靛基质、1%氯化钠乳糖、1%氯化钠纤维二糖、1%氯化钠阿拉伯糖、1%氯化钠蔗糖、1%氯化钠甘露糖、42℃生长试验。(SN标准)。
操作过程:取一内盛2ml无菌生理盐水试管,用接种针从氯化钠营养琼脂平板上挑取部分菌落至无菌生理盐水中,仔细研磨制成0.5麦氏浊度的均一细菌悬液,取一无污染的生化鉴定条,每孔加入100ul菌悬液,其中固体和半固体生化管采用穿剌接种,鸟氨酸、精氨酸、赖氨酸和氨基酸对照需加灭菌石蜡覆盖液面。接种完后做好标记,盖上盖子,放入底托中,放置36℃±1℃培养(42℃生长置42℃培养)。培养结束后,记录试验结果。具体试验结果如图8:

霍乱弧菌非01生化鉴定结果表
|
生化项目 |
结果判定 |
生化形状 |
生化项目 |
结果判定 |
生化形状 |
|
ONPG |
+ |
黄色 |
8%氯化钠蛋白胨水 |
﹣ |
不生长 |
|
尿素酶 |
﹣ |
黄色 |
10%氯化钠蛋白胨水 |
﹣ |
不生长 |
|
明胶 |
+ |
液态 |
1%氯化钠甘露醇 |
+ |
红色 |
|
鸟氨酸 |
+ |
紫色 |
1%氯化钠乳糖 |
﹣ |
不变色 |
|
赖氨酸 |
+ |
紫色 |
1%氯化钠纤维二糖 |
﹣ |
不变色 |
|
氨基酸对照 |
﹣ |
黄色 |
1%氯化钠阿拉伯糖 |
﹣ |
不变色 |
|
精氨酸 |
﹣ |
黄色 |
1%氯化钠蔗糖 |
+ |
红色 |
|
无盐蛋白胨水 |
+ |
生长变浑浊 |
靛基质 |
+ |
红色环 |
|
2%氯化钠蛋白胨水 |
+ |
生长变浑浊 |
42℃生长试验 |
+ |
生长变浑浊 |
|
6%氯化钠蛋白胨水 |
﹣ |
不生长 |
氧化酶 |
+ |
紫色 |
|
注:+表示阳性;﹣表示阴性 |
|||||
注意事项: 1.靛基质试验过程中,在培养结束后需加Kovacs氏靛基质试剂2-4滴,混匀后4h内观察结果;2.鸟氨酸、精氨酸、赖氨酸和氨基酸对照需加灭菌液体石蜡覆盖液面。
三、结果总结
霍乱弧菌在TCBS上呈圆形,表面光滑,黄色,直径2mm~3mm;在庆大霉素琼脂培养基上略带青灰色,半透明,扁平微隆起,如延长培养或室温放置,菌落中心形成黑色金属碲沉淀;在氯化钠三糖铁斜面上的反应为底层黄色,斜面黄色,不产生硫化氢,不产气;在氯化钠营养琼脂培养基上纯化培养后菌落呈圆形,边缘半透明中央不透明,直径为3 mm左右;经革兰氏染色试验鉴定为革兰氏阴性,呈弧形或弯曲状;在氧化酶试纸上呈紫色,为阳性实验结果;在无盐蛋白胨胨水和2%氯化钠蛋白胨水中生长;6%氯化钠蛋白胨水、8%氯化钠蛋白胨水生长旺盛为阳性和10%氯化钠蛋白胨水中不生长;ONPG为阳性;尿素酶为阴性;明胶为阳性;鸟氨酸、赖氨酸脱羧酶阳性;氨基酸对照和精氨酸为阴性;蔗糖、甘露醇为阳性;乳糖、纤维二糖和阿拉伯糖为阴性;靛基质试验为阳性;在42℃恒温培养箱中生长。除上述试验,对霍乱弧菌的检测亦可选做血清学分型等相关试验。